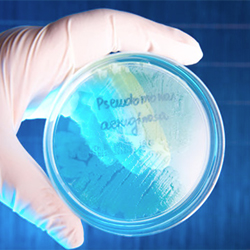

By IDSE News Staff
A five-year trend study shows a rebound in inappropriate use of antibiotics after an early pandemic dip, and consequently a need to tackle overuse in all patients during viral illness outbreaks.

America is going the wrong way when it comes to prescribing antibiotics, with one in four prescriptions written being inappropriate for the patient’s condition, according to the new study from a team from the University of Michigan, Northwestern University and Boston Medical Center (Clin Infect Dis 2024 Apr 15. ciae135. doi:10.1093/cid/ciae135).
In fact, the percentage of inappropriate antibiotic prescriptions was even higher in December 2021 than it was before the pandemic began, the study shows. The percentage of people receiving antibiotics for inappropriate reasons decreased slightly in the early months of the pandemic, when far fewer people sought medical care for infectious or noninfectious conditions, the data show. But it got back on the wrong track soon after.
The study used data from more than 37.5 million children and adults covered by private insurance or Medicare Advantage plans from 2017 to 2021. Patients received antibiotic prescriptions from both in-person and telehealth visits.
The team reviewed any new diagnosis given to each patient on the day they received a prescribed antibiotic, or in the three days prior to getting the prescription. If none of these diagnoses justified the use of antibiotics, the researchers classified the prescription as inappropriate.
“Our study shows that the decline in exposure to inappropriate antibiotic prescriptions during the pandemic was only temporary,” said lead author Kao-Ping Chua, MD, PhD, a pediatrician and healthcare researcher in the Department of Pediatrics at the U-M Medical School, in Ann Arbor. “Our findings highlight the continued importance of quality improvement initiatives focused on preventing unnecessary antibiotic prescribing and antimicrobial resistance, which kills 48,000 Americans per year.” Dr. Chua is also a member of the Susan B. Meister Child Health Evaluation and Research Center, and the U-M Institute for Healthcare Policy and Innovation, and has a joint appointment in the U-M School of Public Health.
Key findings of the study include the following:
- In all, 60.6 million antibiotic prescriptions were dispensed during the study period of January 2017 to December 2021. The proportion that was inappropriate rose from 25.5% to 27.1% during this period.
- The proportion of patients given inappropriate antibiotics was 1.7% in December 2019, dipped to 0.9% in April 2020—largely because fewer people get antibiotics in general—and returned to 1.7% by December 2021.
- Some groups of people were more likely to receive inappropriate antibiotics. At the end of 2021, 30% of antibiotics for older adults with Medicare Advantage coverage were inappropriate, compared with 26% of antibiotics for adults with private health insurance and 17% of antibiotics for children with private insurance.
- Among the diagnoses listed for patients who received antibiotics for inappropriate reasons, "contact with and suspected exposure to COVID-19" was one of the top two most common reasons from March 2020 through December 2021. There is no evidence that taking antibiotics after an exposure can reduce the risk of developing COVID-19.
- Of all the inappropriately prescribed antibiotics dispensed in the second half of 2021, 15% were for a COVID-19 infection. Furthermore, COVID-19 infections accounted for 2% of all antibiotic prescribing—regardless of appropriateness—from March 2020 through December 2021.
- Telehealth appointments accounted for 9% of all inappropriate antibiotic prescriptions in the latter half of 2021, down somewhat from 2020. There were almost no telehealth-based antibiotic prescriptions before March 2020.
- For 28% to 32% of the antibiotic prescriptions filled by patients in the study period, there was no diagnosis available to judge appropriateness, potentially because the patient received the prescription at an appointment that didn't get billed to their insurance or it was a refill of a past prescription. The percentage was especially high in the first months of the pandemic.
- Of all the study patients, 45% received antibiotics at least once in the five-year period, and 13% received them four times or more.